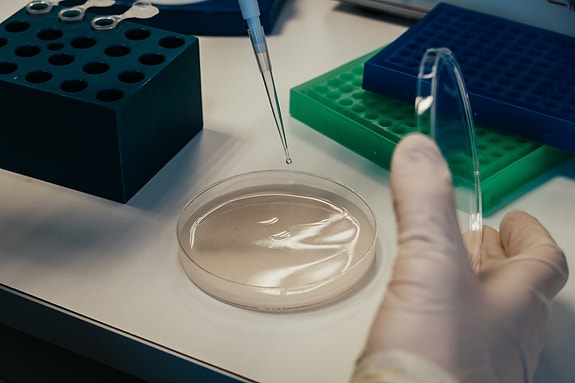
Bilde 1 av 3 i jobbannonse-galleriet

Laboratoriearbeid/Administrasjon
Matråd AS
- Frist 23.1.2026
- Ansettelsesform Fast
Vil du være med å videreutvikle Matråd AS?
Om stillingen
Som vår nye medarbeider vil du være med på å videreutvikle Matråd AS inn i fremtiden. Du vil kombinere laboratoriearbeid med administrative oppgaver, og få store muligheter for faglig og personlig utvikling.
Stillingen passer spesielt godt for deg som liker å jobbe selvstendig i et spennende fagmiljø med korte beslutningsveier.
Arbeidsoppgaver
Laboratoriearbeid
Administrative oppgaver og kundekontakt
Bidra til god samhandling mellom analyse og rådgivning
Videreutvikling av våre tjenester
Aktiv rolle i utviklingen av selskapet
Vi ser etter deg som
Er serviceinnstilt og fleksibel
Har gode samarbeids – og kommunikasjonsevner
Trives med ansvar og varierte oppgaver
Liker å jobbe selvstendig i små miljøer
Er nytenkende og løsningsorientert
Vi tilbyr
En nyopprettet, variert stilling, hvor du selv kan påvirke arbeidshverdagen
En solid, fremoverlent og spennende bedrift
Et faglig sterkt og engasjert arbeidsmiljø
God opplæring og oppfølging
Gode pensjons – og forsikringsordninger
Ønskede kvalifikasjoner
Relevant utdanning/erfaring innen laboratorieanalyse, mattrygghet, kvalitetssikring og/eller administrative oppgaver
Gode IT-ferdigheter
Gode norskkunnskaper
Førerkort klasse B
JobbMatch
Er du en god match for denne stillingen?
JobbMatch ser på erfaringen og egenskapene dine – og sjekker hvor godt du passer.
Om arbeidsgiveren
Matråd AS er en kompetansebedrift innen næringsmiddel og vann. Vi er fire ansatte og lokalisert på Røros. Vår visjon er å bidra til god matkvalitet gjennom analyse og rådgiving. Matråd AS har et akkreditert laboratorium iht. ISO 17025 i tillegg til konsulentvirksomhet. Våre verdier er tillit og fleksibilitet, noe vi i Matråd AS setter høyt og som gjenspeiler alt vi gjør.
- Sektor: Privat
- Sted: Havsjøveien 309, 7374 Røros
- Hjemmekontor: På kontoret
- Bransje: Konsulent og rådgivning, Matvareproduksjon og -industri
- Stillingsfunksjon: Forretningsutvikling og strategi, Kundeservice, Kvalitetssikring
- Arbeidsspråk: Norsk
Nøkkelord
administrative oppgaver, kundekontakt, mattrygghet, laboratoriearbeid, rådgivning
(1/3)
Annonseinformasjon
- FINN-kode 444685200
- Sist endret